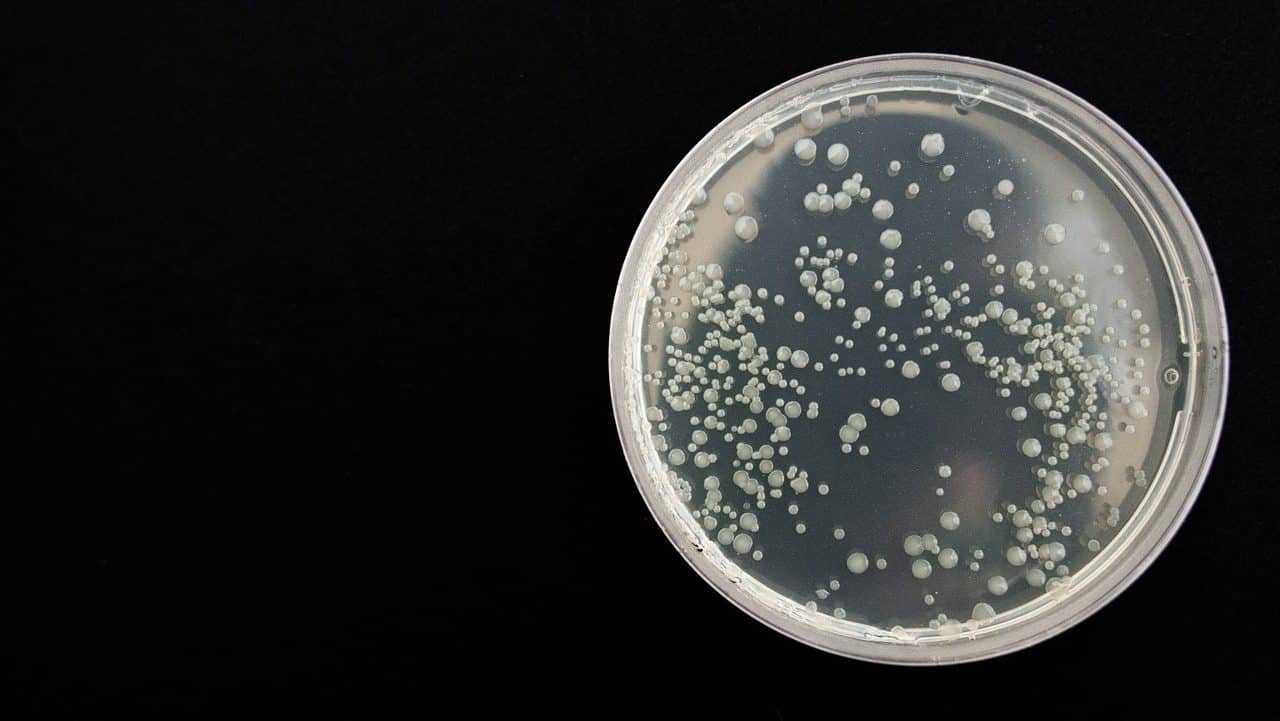
RISIKO UNFRUCHTBARKEIT -CHLAMYDIEN SIND DIE HÄUFIGSTE SEXUELL ÜBERTRAGBARE INFEKTION IN DEUTSCHLAND img-4

Die Inhalte dieser Website wurden nach bestem Wissen erstellt, dennoch bürgen wir nicht für die Richtigkeit. Gewarnt wird ausdrücklich vor Selbstdiagnosen und -therapien auf Grundlage dieser Seiten. Die Inhalte verstehen sich ausschließlich als vertiefende bzw. laienverstaendliche Informationen allgemeiner Art rund um die Themen Schwangerschaft, Geburt, Babys, Kleinkinder und Familie.
Bei gesundheitlichen Problemen ersetzt diese Website in keinem Fall einen Arztbesuch. Wendet Euch bitte bei Erkrankungen oder Unklarheiten unbedingt an einen Arzt Eures Vertrauens.
Adeba.de gibt es seit 1997 und ist eine der ältesten Seiten zum Thema Kinderwunsch, Schwangerschaft, Geburt, Babies, Kleinkinder und Familie. Mit großem Forum und viel Privatsphäre.
Unabhängig und neutral. Es ist ein rein privates Projekt, welches als Hilfe für viele Mütter in deutschsprachigen Raum gedacht ist.
Du kannst uns erreichen: Kontaktformular
© Adeba immer für Dich da.